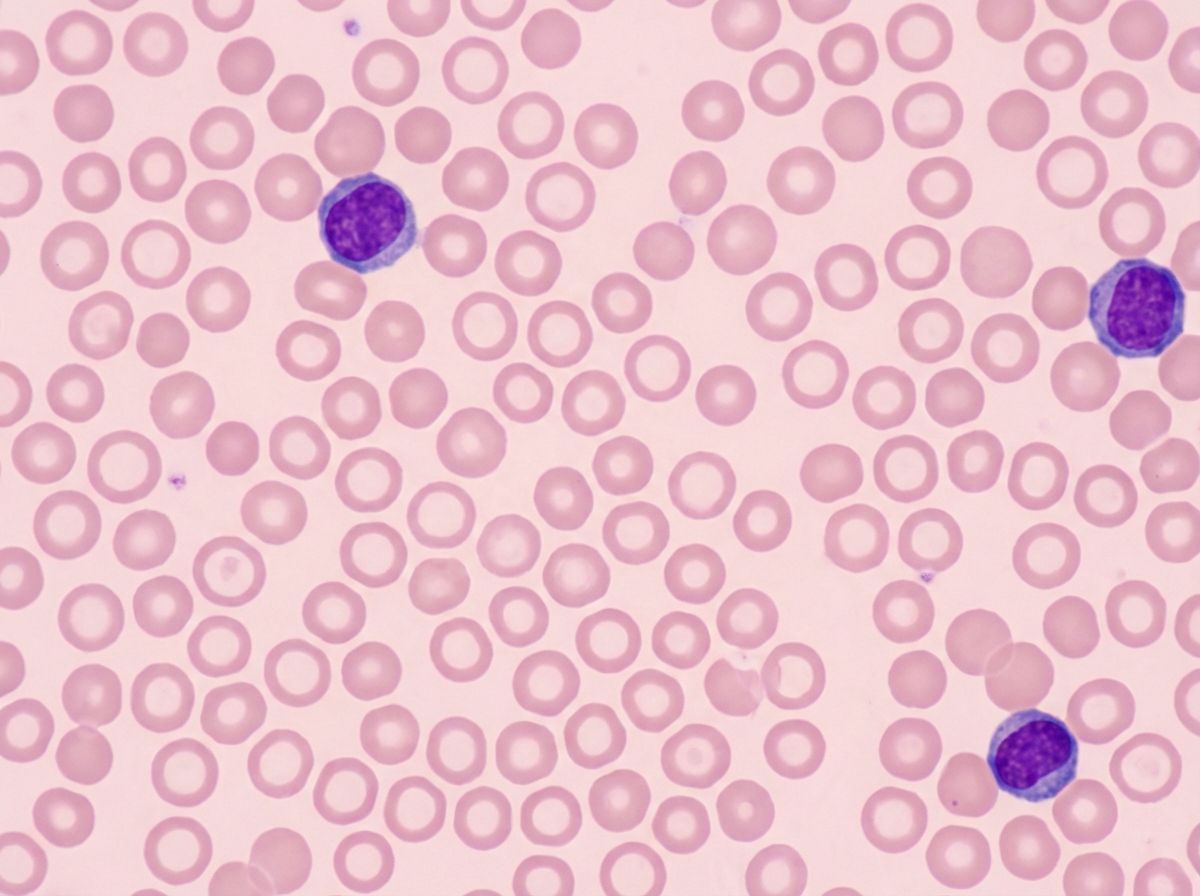
Image for question 212

A 45-year-old man presents with worsening joint pain and stiffness. Past medical history is significant for rheumatoid arthritis, diagnosed 3 months ago and managed with celecoxib and methotrexate, and occasional gastric reflux, managed with omeprazole. His vitals are a pulse of 80/min, a respiratory rate of 16/min, and blood pressure of 122/80 mm Hg. On physical examination, the left wrist is swollen, stiff, and warm to touch, and the right wrist is red and warm. There is limited active and passive range of motion at the proximal interphalangeal and metacarpophalangeal joints of both hands. The remainder of the examination is unremarkable. A plain radiograph of the hands shows progressive degeneration of multiple joints. Another drug, etanercept, is added to help control progressive arthritis. Which of the following diagnostic tests should be ordered before starting this new medication in this patient?
A 54-year-old man with a past medical history significant for hypertension, type 2 diabetes, and chronic obstructive pulmonary disease presents with complaints of nausea and abdominal pain for the past month. The pain is located in the epigastric region and is described as “burning” in quality, often following food intake. The patient denies any changes in bowel movements, fever, or significant weight loss. Medications include metformin, lisinopril, hydrochlorothiazide, albuterol inhaler, and fluconazole for a recent fungal infection. Physical examination was unremarkable except for a mildly distended abdomen that is diffusely tender to palpation and decreased sensation at lower extremities bilaterally. A medication was started for the symptoms. Two days later, the patient reports heart palpitations. An EKG is shown below. Which of the following is the medication most likely prescribed?

Several weeks after starting a new medication for rheumatoid arthritis, a 44-year-old woman comes to the physician because of painful ulcers in her mouth. Oral examination shows inflammation and swelling of the tongue and oropharynx and ulcers on the buccal mucosa bilaterally. Skin examination shows soft tissue swelling over her proximal interphalangeal joints and subcutaneous nodules over her elbows. Serum studies show an alanine aminotransferase level of 220 U/L, aspartate aminotransferase level of 214 U/L, and creatinine level of 1.7 mg/dL. Which of the following is the most likely primary mechanism of action of the drug she is taking?
A 4-year-old boy is brought to the physician by his mother because of left-sided neck swelling that has slowly progressed over the past 4 weeks. He has no history of serious illness. Temperature is 38°C (100.4°F). Physical examination shows a non-tender, mobile mass in the left submandibular region with overlying erythema. A biopsy of the mass shows caseating granulomas. Pharmacotherapy with azithromycin and ethambutol is initiated. This patient is most likely to experience which of the following adverse effects related to ethambutol use?
A 47-year-old woman with a history of recent gastric bypass surgery presents for a follow-up visit. 8 months ago, she underwent gastric bypass surgery because she was struggling with maintaining her BMI below 42 kg/m². She previously weighed 120 kg (265 lb), and now she weighs 74.8 kg (165 lb). She says that she has low energy and is easily fatigued. These symptoms have become progressively worse over the past month. She is struggling to get through the day and sometimes has to nap before she can continue with her work. She has also recently noticed that she gets cramps in her legs, especially after a long day. The patient is afebrile and vital signs are within normal limits. Physical examination is unremarkable. Her hemoglobin is 9.5 mg/dL with an MCV of 75 fl. Her peripheral smear is shown in the exhibit. Which of the following supplements would most likely improve this patient’s symptoms?
A 62-year-old man is brought to the emergency department from a senior-care facility after he was found with a decreased level of consciousness and fever. His personal history is relevant for colorectal cancer that was managed with surgical excision of the tumor. Upon admission, he is found to have a blood pressure of 130/80 mm Hg, a pulse of 102/min, a respiratory rate of 20/min, and a body temperature 38.8°C (101.8°F). There is no rash on physical examination; he is found to have neck rigidity, confusion, and photophobia. There are no focal neurological deficits. A head CT is normal without mass or hydrocephalus. A lumbar puncture was performed and cerebrospinal fluid (CSF) is sent to analysis while ceftriaxone and vancomycin are started. Which of the following additional antimicrobials should be added in the management of this patient?
A 72-year-old man has been recently diagnosed with stage 3 squamous cell carcinoma of the oral cavity. After the necessary laboratory workup, concurrent chemoradiation therapy has been planned. Radiation therapy is planned to take place over 7 weeks and he will receive radiation doses daily, Monday–Friday, in 2.0 Gy fractions. For concurrent chemotherapy, he will receive intravenous cisplatin at a dosage of 50 mg/m2 weekly for 7 weeks. Which of the following best explains the mechanism of action of the antineoplastic drug that the patient will receive?
A 66-year-old man comes to the physician because of a 3-month history of constipation and streaks of blood in his stool. He has had a 10-kg (22-lb) weight loss during this period. Colonoscopy shows an exophytic tumor in the sigmoid colon. A CT scan of the abdomen shows liver metastases and enlarged mesenteric and para-aortic lymph nodes. A diagnosis of stage IV colorectal cancer is made, and palliative chemotherapy is initiated. The chemotherapy regimen includes a monoclonal antibody that inhibits tumor growth by preventing ligand binding to a protein directly responsible for epithelial cell proliferation and organogenesis. Which of the following proteins is most likely inhibited by this drug?
A 65-year-old male with diffuse large B cell lymphoma is treated with a chemotherapy regimen including 6-mercaptopurine. Administration of which of the following agents would increase this patient’s risk for mercaptopurine toxicity?
A 40-year-old woman comes to the physician for the evaluation of a 4-month history of reddening of the nose and cheeks. She has no itching or pain. She first noticed the redness while on a recent holiday in Spain, where she stayed at the beach and did daily wine tastings. She has tried several brands of sunscreen, stopped going outside in the middle of the day, and has not drunk alcohol since her trip, but the facial redness persists. She has no history of serious illness. Her younger sister has acne vulgaris, and her mother has systemic lupus erythematosus. The patient reports that she has had a lot of stress lately due to relationship problems with her husband. She does not smoke. Her vital signs are within normal limits. Examination shows erythema of the nose, chin, and medial cheeks with scant papules and telangiectasias. There are no comedones or blisters. The remainder of the examination shows no abnormalities. In addition to behavioral modifications, which of the following is the most appropriate initial treatment?
Antiparasitic drugs (antiprotozoals)
Practice Questions
Antimalarial medications
Practice Questions
Anthelmintics
Practice Questions
Antiseptics and disinfectants
Practice Questions
Antimicrobial stewardship principles
Practice Questions
Empiric antimicrobial selection
Practice Questions
Antimicrobial dosing in special populations
Practice Questions
Antimicrobial pharmacokinetics/pharmacodynamics
Practice Questions
Antimicrobial toxicities
Practice Questions
Antimicrobial allergies and cross-reactivity
Practice Questions
Combination antimicrobial therapy
Practice Questions
Cost-effective antimicrobial strategies
Practice Questions
New antimicrobial development
Practice Questions
Get full access to all questions, explanations, and performance tracking.
Scan to download app
Enter your email to get your 85% OFF code and unlock the full USMLE question bank on the app.